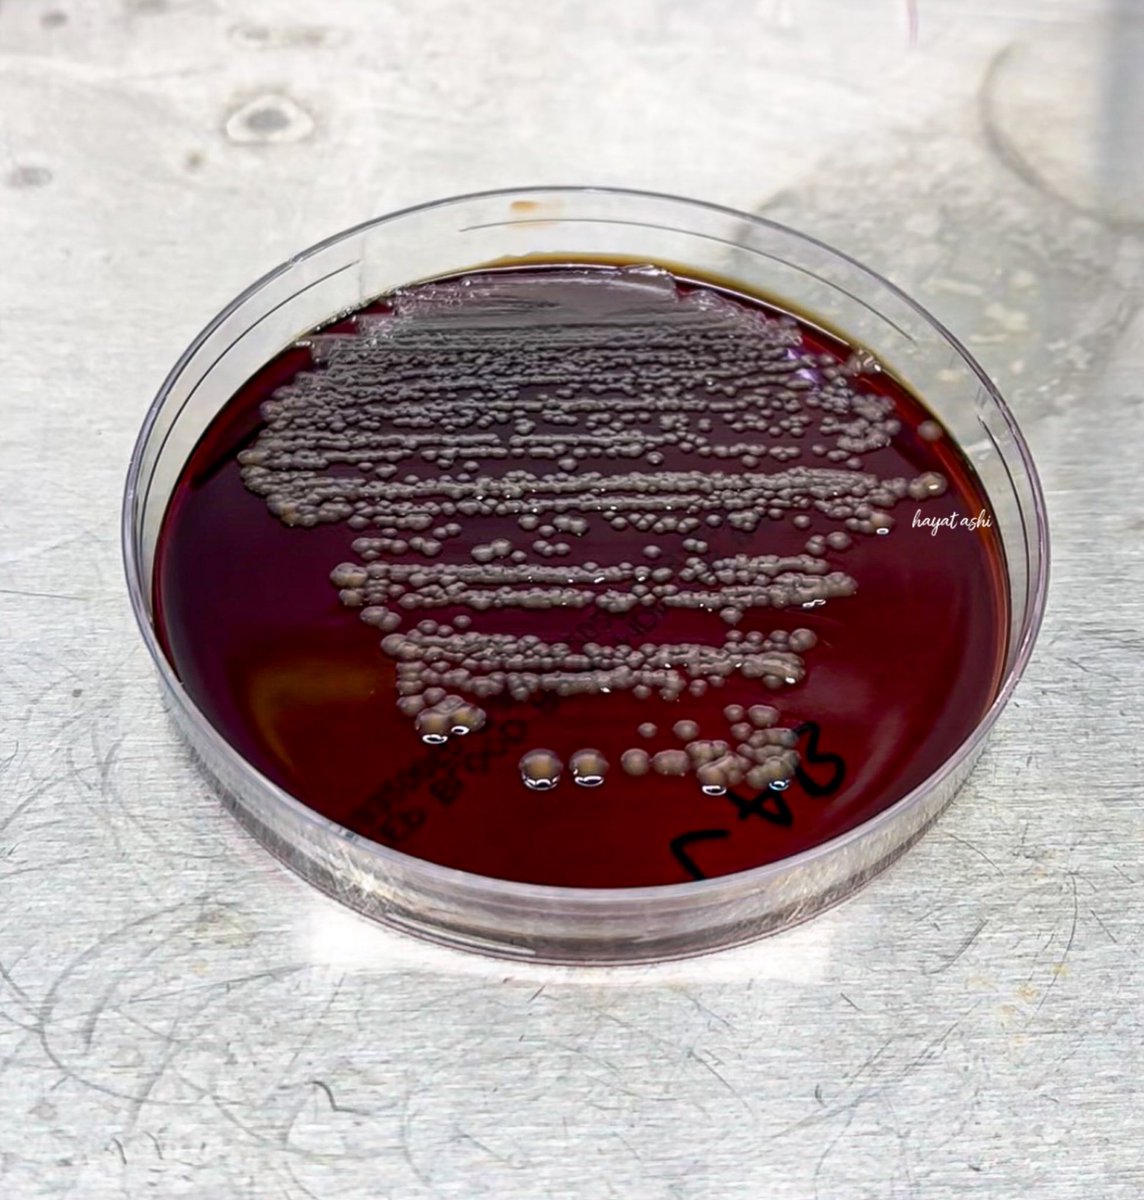

حيث تقوم بتحويل السكريات إلى حمض اللاكتيك وبيروكسيد الهيدروجين وهي مواد تمنع نمو البكتيريا الضارة في الأمعاء
كما تساعد الأمعاء في بناء البطانة الداخلية وتعزيز المناعة وتحسن النشاط العضلي للأمعاء، وتساعد في إنتاج فيتامين K بل وامتصاص الأمعاء له بحيث يمكن لجسم الإنسان استخدامه
كما تساعد الأمعاء في بناء البطانة الداخلية وتعزيز المناعة وتحسن النشاط العضلي للأمعاء، وتساعد في إنتاج فيتامين K بل وامتصاص الأمعاء له بحيث يمكن لجسم الإنسان استخدامه
والتقليل من أعراض القولون العصبي، وعلاج للإسهال، وهذه البكتيريا لا يمكن أن تؤذي الأمعاء نفسها في أعدادها الطبيعية، حيث يعمل النشاط العضلي في الأمعاء على التحكم بأعداد البكتيريا، ومخاط البطانة الداخلية يمنع تلك البكتيريا من التأثير المباشر على الأمعاء كما توجد بالأمعاء أجسام مضادة
جاري تحميل الاقتراحات...